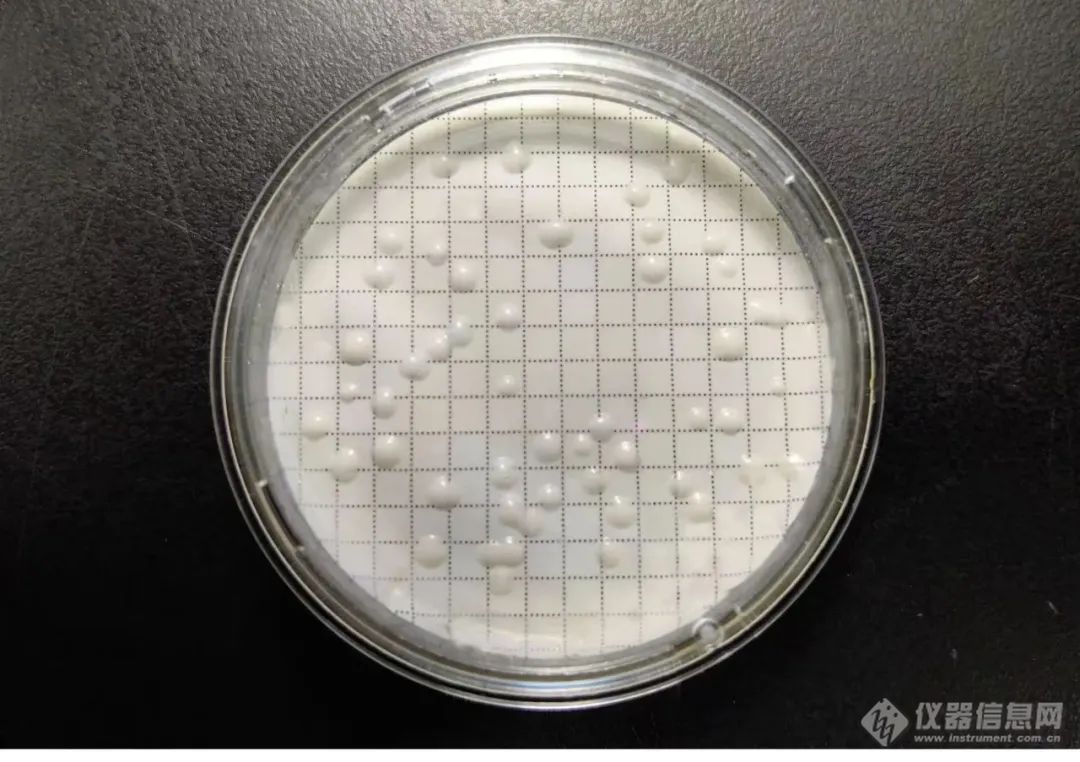

检验流程中通过膜过滤用意将微生物和检品折柳,再通过作育或其他举措确认被拘押微生物的数目。
微孔滤膜功能和对检品的兼容性对微生物检测的结果起到庞大的影响,那么咱们该当如何拔取微生物检测微孔滤膜呢?
《中邦药典》和GB4789系列尺度均划定微生物检测滤膜孔径不大于0.45μm。过大的孔径存正在被微生物穿透的危急,而过小的孔径则会消重过滤的恶果。对待检测微生物穿透的题目,我司过程尝试证明纵然小如寻事除菌过滤器的缺陷短波单胞菌,行使0.45μm滤膜过滤后作育其接收率也正在80%以上,和举措合用性的其他微生物没有显明分别,以是微生物检测并不必要行使更小孔径的滤膜,0.45μm的滤膜便是拔取。02 滤膜材质拔取常睹的微孔滤膜材质包罗搀杂纤维素(MCE)、尼龙(N66)、聚醚砜(PES)、聚偏二氟乙烯(PVDF)和聚四氟乙烯(PTFE)等。
此中MCE滤膜过滤水性溶液恶果高,但化学兼容性差,对抑菌检品吸附强;N66过滤恶果日常,但适合大都有机溶剂和抑菌性检品;PES具备较高的通量和较低的卵白吸附,合用于油性和卵白类检品;PVDF广泛合用于强抑菌性检品;而PTFE合用于极少消融性强的有机溶剂(如:DMSO)。

微生物检测微孔滤膜行使前应无菌,非无菌滤膜正在行使前需用户自行对滤膜举办灭菌(日常为湿热灭菌款式),滤膜日常为高分子会集物产物,其灭菌耐受款式首要为环氧乙烷灭菌和辐照灭菌,湿热灭菌后其滤膜完备性难以保障,且用户需对自行灭菌后的“滤膜的完备功能”举办检修。相较于非无菌滤膜,无菌滤膜正在行使便捷性与质地保障上更具上风。部门无菌滤膜还能团结取膜器行使,裁减职员接触滤膜的污染危急。
现行版《中邦药典》划定“试验组菌落数减去供试品比较组菌落数的值与菌液比较组菌落数的比值应正在0.5-2界限内。“而ISO 7704-2023 《Water quality – Evaluation of membrane filters used for microbiological analyses》请求“亲水性滤膜对微生物的接收率应≥0.7。”泰林微生物检测微孔滤膜,参照ISO 7704-2023举办微生物接收率的质地把持,供给更确凿的微生物计数结果。
依照试验需求确认,泰林微孔滤膜的策画有差异颜色,此中白色适合菌落颜色较深的微生物作育;玄色适合菌落颜色较浅的微生物作育;别的,差异类型的微孔滤膜还能够拔取差异巨细的网格,简单用户的微生物侦察与计数。

大浪逐新 万木峥嵘——泰林生物上市五周年暨2024年度总结称誉大会完美落幕
![]()
泰林生物联袂太古美味可乐共探数智化微生物检测新道途——手艺互换会暨园区敬仰行径完美实行
泰林生物2025年前三季度净利润拉长30%,筹备现金流拉长171.73%
2025CIPM·青岛|泰林生物以数智更始与合规升级回应制药行业高质地生长命题
2025年版《中邦药典》药包材无菌和微生物控制检验法、洋葱伯克霍尔德菌群检验法解析
公司地方:浙江省杭州市滨江区南环道2930号泰林科技园联络人:泰林邮编:310052联络电线